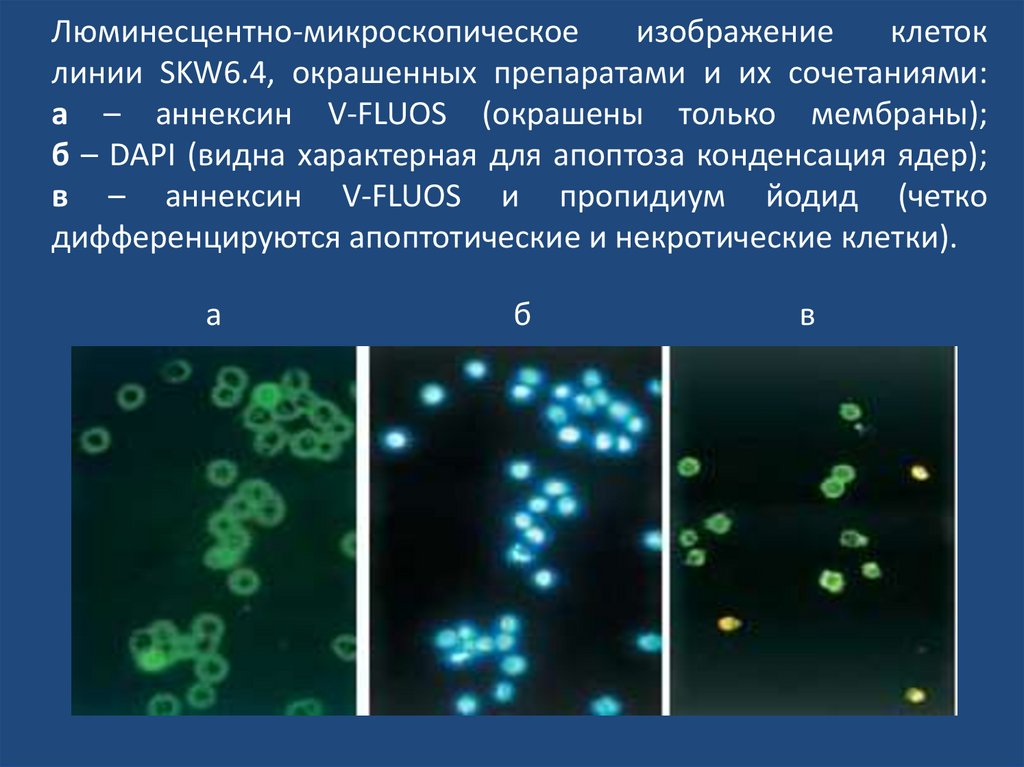

Похожие презентации:
Лабораторная диагностика сифилиса: проблемы и решения
1. Лабораторная диагностика сифилиса: проблемы и решения
Иванов Андрей МихайловичВоенно-медицинская академия
им. С.М. Кирова
2. Заболеваемость сифилисом в Российской Федерации (на 100 тыс. нас.) [1975-2015 гг.]
3. Лабораторная диагностика
4.
5. Проблемные вопросы при серологической диагностике сифилиса
• Активный процесс или анамнестическаяинфекция?
• Реинфекция или рецидив?
• Контроль излеченности?
• Причина серологической резистентности
(замедленной негативации серологических
реакций)?
6.
7.
8.
9.
10.
11.
12.
13. Лабораторные методы диагностики сифилиса
ПрямыеНепрямые (серологические)
Темнопольная
микроскопия
Нетрепонемные
тесты
Прямая иммунофлюоресценция
Трепонемные
тесты
ПЦР
14. Антигены, используемые в серологической диагностике сифилиса
Цельноклеточный трепонемный антиген – взвесь патогенныхT.pallidum штамма Никольс из 7-суточного орхита кролика;
Рекомбинантные и синтетические аналоги антигенов T.pallidum;
Культуральный трепонемный антиген – взвесь смешанных
культур сапрофитных бледных трепонем штаммов VII, VIII, IX и
Рейтера, разрушенные ультразвуком;
Кардиолипиновый антиген – смесь трех высокоочищенных
липидов: кардиолипина, лецитина и холестерина.
15.
Нетрепонемные тесты (НТТ)МР (или РМП) – микрореакция с плазмой и инактивированной
сывороткой
РСКк – реакция связывания комплемента с кардиолипиновым
антигеном
RPR – тест быстрых плазменных реагинов (Rapid Plasma Reagins)
VDRL – Venereal Disease Research Laboratory
TRUST – тест с толуидиновым красным и непрогретой сывороткой
(Toluidin Red Unheated Serum Test)
RST - тест отбора реагинов (Reagin Screen Test)
USR – тест определения активных реагинов плазмы
(Unheated Serum Reagins)
Lues-тест – аналог МР (производства НПО «Диагностические системы»),
Н.Новгород
16.
“Термин “апоптоз” предложен для обозначения до сихпор
недостаточно
понятного
механизма
контролируемого
разрушения
клеток
…
это
активный, по сути программируемый феномен, для
которого доказана возможность активации или
подавления различными стимулами окружающей
среды,
как
физиологическими,
так
и
патологическими”.
Kerr J.F.R., Wyllie A.H., Currie A.R. (из статьи “Апоптоз:
фундаментальный биологический феномен,
широко участвующий в кинетике тканей”, 1972 г.)
17. Апоптоз
Энергозависимый, генетическидетерминированный процесс
упорядоченной гибели отдельных
клеток, который происходит в
нормальных и патологически
измененных тканях эукариотов под
действием внутри- и внеклеточных
стимулов.
18. Сравнительная морфология апоптотического и некротического типов гибели клетки (по: Wyllie et al., 1998)
19. Механизмы программированной гибели клеток
• Внеклеточный (лиганд-рецепторноевзаимодействие)
• Внутриклеточный
- митохондриальные рецепторы (белки
суперсемейства Bcl-2)
- каспазы
- протеазы
- белки теплового шока
20. Морфофункциональные исследования
• Выявление интегральных структурнофункциональных признаков апоптоза• Определение специфичных для апоптоза
изменений плазматической мембраны
клеток
• Оценка митохондриальных процессов
• Изучение характера фрагментации ДНК
21. Морфофункциональные исследования
• Выявление интегральных структурнофункциональных признаков апоптоза• Определение специфичных для апоптоза
изменений плазматической мембраны
клеток
• Оценка митохондриальных процессов
• Изучение характера фрагментации ДНК
22. Люминесцентно-микроскопическое изображение клеток линии SKW6.4, окрашенных препаратами и их сочетаниями: а – аннексин V-FLUOS
(окрашены только мембраны);б – DAPI (видна характерная для апоптоза конденсация ядер);
в – аннексин V-FLUOS и пропидиум йодид (четко
дифференцируются апоптотические и некротические клетки).
а
б
в
23.
Трепонемные тесты на сифилис (ТТ)РСКт – реакция связывания комплемента с трепонемным антигеном
РИБТ (РИТ) – реакция иммобилизации бледных трепонем (Treponema pallidum
TPI - immobilization test)
РИФ – реакция иммунофлуоресценции (Fluorescent treponemal antibody - FTA)
РИФабс
РИФ200
РИФц
РПГА – реакция пассивной гемагглютинации
(Treponema pallidum haemagglutination assay –ТРНА), (Treponema pallidum partiсle
agglutination assay - TPPA)
ИФА – иммуноферментный анализ (Enzymelynced immunosorbent assay - ELISA)
Иммуноблоттинг (Western Blot)
24. Серологическая диагностика сифилиса в Европе, США и России
ESCDC
РФ
Скрининг
РПГА Доп.
VDRL/RPR
или
ИФА IgG
или
РИФ абс
или
ИФА IgМ
VDRL/RPR
+ РИФ абс или РПГА
РМП/RPR
или
ИФА
или
РПГА
Подтверждение
Любой трепонемный
тест, неиспользуемый
в скрининге
или
IgG иммуноблотинг
Те же тесты в той же
лаборатории
Трепонемные тесты
(ИФА, РПГА, РИБТ,
РИФ, КСР)
Оценка
эффективности
терапии
VDRL/RPR
VDRL/RPR
РМП/RPR
25. Интерпретация результатов серологических тестов на сифилис при их комбинированном использовании
Результаты тестированияНТТ
ТТ
Интерпретация
+
- сифилис нелеченый;
- сифилис леченый поздний;
- инфекции, вызванные другими представителями
рода Treponema;
- ложноположительные реакции при иксодовых
клещевых боррелиозах;
- биологические ложноположительные реакции;
ложноположительные
НТТ
и
ТТ
при
аутоиммунных заболеваниях.
–
+
- сифилис успешно леченый;
- поздний сифилис нелеченый;
- первичный сифилис, ранний;
- вторичный сифилис с прозоной;
- ложноположительные ТТ;
- ВИЧ, конечная стадия.
+
–
- биологические ложноположительные реакции
–
- инкубационный сифилис;
- первичный сифилис (очень ранний);
- ВИЧ (феномены Hass и Hicks);
- первичный сифилис после лечения;
- пациент никогда не болел сифилисом
+
–
26. Проблемные вопросы при серологической диагностике сифилиса
• Активный процесс или анамнестическаяинфекция?
• Реинфекция или рецидив?
• Контроль излеченности?
• Причина серологической резистентности
(замедленной негативации серологических
реакций)?
27. Повышение информативности серологической диагностики:
получение искусственных аналогов микробных
антигенов и их использование в диагностических
препаратах
раздельное выявление классов и подклассов
специфических иммуноглобулинов (IgM, IgG1,
IgG2, IgG3, IgG4)
изменение трактовки результатов
серологического тестирования
28.
29. Последовательности аминокислот в естественном липопротеине T.pallidum 17 кДа
12
3
4
5
6
7
8
9
10
11
12
13
14
15
16
17
18
19
20
m
k
g
s
v
r
a
l
c
a
f
l
g
v
g
a
l
g
s
a
21
22
23
24
25
26
27
28
29
30
31
32
33
34
35
36
37
38
39
40
l
c
v
s
c
t
t
v
c
p
h
a
g
k
a
k
a
e
k
v
41
42
43
44
45
46
47
48
49
50
51
52
53
54
55
56
57
58
59
60
e
c
a
l
k
g
g
i
f
r
g
t
l
p
a
a
d
c
p
g
61
62
63
64
65
66
67
68
69
70
71
72
73
74
75
76
77
78
79
80
i
d
t
t
v
t
f
n
a
d
g
t
a
q
k
v
e
l
a
l
81
82
83
84
85
86
87
88
89
90
91
92
93
94
95
96
97
98
99
100
e
k
k
s
a
p
s
p
l
t
y
r
g
t
w
m
v
r
e
d
101
102
103
104
105
106
107
108
109
110
111
112
113
114
115
116
117
118
119
120
g
i
v
e
l
s
l
v
s
s
e
q
s
k
a
p
h
e
k
e
121
122
123
124
125
126
127
128
129
130
131
132
133
134
135
136
137
138
139
140
l
y
e
l
i
d
s
n
s
v
r
y
m
g
a
p
g
a
g
k
141
142
143
144
145
146
147
148
149
150
151
152
153
154
155
156
p
s
k
e
m
a
p
f
y
v
i
k
k
t
k
k
30. Сравнительная характеристика иммунореактивности пептидов T.pallidum из области 17 кД
1,4ОП, 492 нм
1,2
1
0,8
0,6
0,4
0,2
0
Sif-21 Sif-22
Sif-23
положительные с-ки
отрицательные с-ки
Sif-24
пептиды
Sif-31
Sif-33
31. Эпитопное картирование трепонемного антигена 17 кД
Последовательность аминокислот (десятки)пептиды
1
2
3
4
5
6
7
8
9
10
11
12
Общая последовательность 156 аминокислот
Sif-22
(26-46)
Sif-33
(34-93)
Sif-31
(52-93)
Sif-24
(102-121)
Sif-23
(126-156)
Sif-21
(138-156)
13
14
15
16
32. Повышение информативности серологической диагностики:
получение искусственных аналогов микробных
антигенов и их использование в диагностических
препаратах
раздельное выявление классов и подклассов
специфических иммуноглобулинов (IgM, IgG1,
IgG2, IgG3, IgG4)
изменение трактовки результатов
серологического тестирования
33. Биологические свойства подклассов иммуноглобулинов человека
Биологическиесвойства
Подклассы IgG
IgG1
IgG2
IgG3
IgG4
Содержание в сыворотке, мг/мл
7,1
3,0
0,80
0,40
Содержание в сыворотке, %
58-71
19-31
5-10
3-6
Экспрессия на В-лимфоцитах, %
40
48
8
1
% плазмоцитов-продуцентов
64
26
8
1
Частота миелом-продуцентов, %
60-70
15-20
4-8
2-6
Связывание C1q
++
+
+++
-
Связывание с FcγR-I
+++
+
+++
+
Связывание с FcγR-II
++
+
++
+
Связывание с FcγR-III
++
+
++
+
Связывание с РФ
+
+
-
+
Связывание с белком А
++
++
-
++
Связывание с белком G
++
++
++
++
Перенос через плаценту
++
+
++
++
Время полужизни в крови
12-21
12-21
7-8
11-21
Блокир. активность при аллергии
-
-
-
+
Функциональная валентность
2
2
2
1
34. Панель использованных трепонемных антигенов
Искусственныйаналог
Естественный
антиген
Молекулярная
масса, кД
Рекомбинантный
белок р15
Трр15
15
Рекомбинантный
белок р17
Трр17
17
Синтетический пептид
Sif-13
Трр41
41
Рекомбинантный
белок р47
Трр47
47
35. Структура обследованных больных
Период заболеванияКоличество обследуемых
Вероятный инкубационный
период
14
Первичный сифилис
30
Вторичный свежий
сифилис
69
Ранний скрытый сифилис
54
Вторичный рецидивный
сифилис
Поздний скрытый сифилис
Всего
72
8
247
36.
• 1. При проведении успешной противомикробнойтерапии уровни антител к антигену 41 кД, по
сравнению с антителами к антигенам 15, 17 и 47 кД
снижаются в более ранние сроки (до 3-х месяцев).
Сохранение позитивности результатов ИФА в
отдаленные после окончания лечения сроки связано
с антителами, специфичными антигену 17 кД;
• 2. Антитела IgG3 и IgM, направленные к антигенам
15, 17, 41 и 47 кД после лечения элиминируются в
течение трех месяцев. Позитивность результатов
ИФА с трепонемными липопротеинами в более
поздние сроки обусловлена антителами IgG1
подкласса.
37. Контроль эффективности лечения
Диагностическая задачаДинамика противотрпонемных
иммуноглобулинов
Используемые
серологические
показатели, ИФА
IgG1-, IgG3-, IgMантитела к антигену 41 кД
Результаты исследования в
динамике
Отрицательная
динамика уровней антител
Уровни антител
не снижаются
интерпретация
Примечания
Лечение эффективно
Лечение не эффективно
Целесообразно
определение тактики ведения пациента в процессе комплексного
динамического
наблюдения
38. Структура обследованных беременных
ДиагнозКоличество
%
Вторичный сифилис
22
19,6
Ранний скрытый
сифилис
30
26,8
«Серорезистентность»
12
10,7
Профилактическое
лечение
48
42,9
ВСЕГО
112
100,0
39. Доля проб сывороток крови, реагирующих с трепонемными антигенами, %
диагноз1
Количество антигенов
2
3
4
Вторичный
сифилис
(n=22)
0
0
16,7
83,3
Ранний
скрытый сифилис (n=30)
0
0
33,3
66,7
«Серорезистентность»
(n=60)
11,5
30,8
42,3
15,4
40. Относительное разнообразие противотрепонемных сывороточных антител в зависимости от клинического диагноза
количество серологических маркеровв ИФА
Относительное разнообразие противотрепонемных сывороточных
антител в зависимости от клинического диагноза
12
10
8
6
4
2
0
вторичный сифилис
ранний скрытый сифилис
профилактическое
лечение
серорезистентность
41. Уточнение варианта течения инфекции (имеются сведения об анамнестической инфекции)
Диагностическая задачаВыявление причины сохранения
положительных
результатов
в
серологических
тестах
(после
специфической
терапии)
Используемые
серологические
показатели, ИФА
IgG1-, IgG3-,
IgG4-, IgMантитела к антигенам 15, 17, 41,
47 кД
Результаты исследования (количество выявленных серологических маркеров)
интерпретация
(прогноз сохранения жизнеспособного возбудителя)
7 и более
положительный
5-6
сомнительный
4 и менее
отрицательный
Примечания
Необходимо лечение (скрытое
течение сифилиса)
Тактика определяется при
динамическом
наблюдении
Лечение не целесообразно
42. Наиболее информативные показатели:
Х9 - Уровни IgG1-антител к антигену 41 кД (ед. ОП);Х2 - Количество серологических маркеров в ИФА
(всего 16);
Х7 - Уровни IgG1-антител к антигену 17 кД (ед. ОП);
Х4 - Динамика комплекса серологических реакций
(при исследовании парных сывороток крови с
интервалом 3 мес.);
Х10 - Уровни IgG3-антител к антигену 41 кД (ед. ОП).
43. Формулы линейно-дискриминантных функций, рассчитываемые для дифференциальной диагностики:
F1 = – 0,67х9 – 0,32х2 + 0,5х7 – 0,43х4 – 0,33х10;F2 = – 0,47х9 + 1,05х2 + 0,24х7 – 0,21х4 – 0,29х10.
44. Решение диагностической задачи:
Root 1 vs. Root 23,5
3,0
2,5
2,0
1,5
Root 2
1,0
0,5
0,0
-0,5
-1,0
-1,5
-2,0
-2,5
-3,0
-6
-5
-4
-3
-2
-1
Root 1
0
1
2
3
4
G_1:1
G_2:2
G_3:3
45. Сведения о гомологии трепонемных антигенов и белков организма человека
Трепонемный антигенГомология с белками
макроорганизма
Литературный
источник
Трр17
?
-
Трр47
Иммунодоминантный
участок липопротеина
(PGTEYT) идентичен
аналогичной
последовательности
фибронектина
соединительной ткани
млекопитающих
Baughn R.E., Jiang A., Abraham
R. et al. Molecular mimicry
between an immunodominant
amino acid motif on the 47-kDa
lipoprotein of Treponema pallidum
(Tpp47) and multiple repeats of
analogous sequenses in
fibronectin // J. Immunol. - 1996. Vol.157, №2. - P. 720-731.
46. Сведения о составе ИФА тест-систем, представляемые в инструкциях производителей
Производительтест-системы
Антигенный состав
иммуносорбента
Конъюгат
1.
Рекомбинантные антигены - аналоги
трансмембранных
белков
возбудителя сифилиса Treponema
рallidum
Смесь моноклональных антител мыши
против иммуноглобулинов G и М
человека,
конъюгированных
с
пероксидазой хрена
2.
Рекомбинантные антигены:
Т. рallidum
Антивидовые
антитела,
конъюгированные с пероксидазой хрена
3.
Сорбирована смесь рекомбинантных
белков, соответствующих антигенам
р17, р15, р47 и р45 T. pallidum
Нет данных
4.
Сорбируются рекомбинантные белки
TmpA, p15, p17, p47 Treponema
pallidum
Антитела против IgG и IgM человека,
меченые пероксидазой
5.
Рекомбинантные антигены
Treponema pallidum
Конъюгат – моноклональные антитела
мыши к IgG человека, конъюгированные
с пероксидазой хрена
6.
Рекомбинантныме белки pTp17 и
pTp47 аналоги антигенов
T. pallidum
Смесь рекомбинантных полипептидов –
аналогов
белков
Т.
pallidum,
конъюгированных с пероксидазой хрена
7.
Антигены полученные из
Т. Pallidum.
Антитела к человеческим иммуноглобулинам
конъюгированных
с
пероксидазой хрена
47. Пример расположения антигенов в иммуноблоттинге
TpN47TpN17
стрептавидин
Контроли
± 1+ 3+
TmpA
TpN15
Антигены
48. Оценка результатов
отрицательныйконтроль
положительный
контроль
положительный
результат
сомнительный
результат
отрицательный
результат
49. Структура обследованных пациентов (беременные)
ДиагнозКоличество
%
Вторичный сифилис
24
14,3
Ранний скрытый
сифилис
32
19,0
«Серорезистентность»
112
66,7
ВСЕГО
168
100,0
50. Чувствительность серологических методов диагностики у различных категорий беременных, %
Группыпациентов
РМП
РСКт
РСКк
РПГА
(ТРРА)
ИФА
РИФ
абс.
Вторичный
сифилис,
n=24
100,0
100,0
100,0
100,0
100,0
100,0
Ранний
скрытый
сифилис,
n=32
93,5
96,9
93,5
100,0
100,0
100,0
«Серорезис
тентность»,
n=112
59,8
86,6
63,3
100,0
100,0
100,0
51. Доля проб сывороток крови, реагирующих с трепонемными антигенами в иммуноблоттинге, %
Результаты исследованиядиагноз
recomBlot Treponema recomBlot Treponema
IgМ
IgG
Вторичный сифилис
(n=24)
29,2
100,0
Ранний скрытый
сифилис (n=32)
12,5
100,0
Серорезистентность
(n=112)
8,0
61,6
52. Возможный алгоритм серологической диагностики сифилиса у беременных
Скрининг(ИФА, РПГА, ТРРА)
+
-
Иммуноблоттинг
Сифилис исключается
+
Неопределенный
Специфическое лечение
Динамическое наблюдение
53. Алгоритм иммунологического обследования при сифилисе
Клинико-лабораторная и серологическаядиагностика сифилиса
(скрининг + верификация)
Положительный
результат
(сифилис)
Отрицательный
результат
Сифилис
исключается
Определение
IFN-γ, IL-1β, IL-2, ФЧ
Выраженных изменений
иммунологических показателей
не выявлено
IFN-γ ↑, IL-1β ↑, IL-2 ↑,
ФЧ ↓
Вероятность развития
серорезистентности низкая
Вероятность развития
серорезистентности
высокая
54.
Значение дифференцированного определениятрепонемоспецифических IgM и IgG – антител
в диагностике сифилиса
• Длительное сохранение IgM – AT
после лечения на фоне высоких
титров IgG
истинная
серорезистентность
• Сохранения продукции IgG на
фоне отсутствия IgМ
относительная
серорезистентность
• Положительный результат
IgМ –теста после серии негативных
анализов на фоне невысоких титров IgG
реинфекция
• Выявление IgМ – АТ у новорожденного
(обнаружение IgG – АТ имеет
вспомогательное значение; необходимо
сравнить величину титров IgG – АТ
у матери и ребенка)
врожденный сифилис
55.
Динамика трепонемных тестов на сифилисуровни
АТ
IgG (ИФА, КСР,
РИТ, РПГА)
IgM (ИФА)
1 2
3 4 5
6 7
8
Сифилис I
Инкубацион-Сифилис I
ный период Серонегатив- Серопозитивный
ный
9 недель
1
2 3
Сифилис II
4
10 20 30 40 лет
Сифилис III
56. Частота выявления IgМ-положительных сывороток крови в различные периоды сифилиса
10090
80
70
%
60
50
40
30
20
10
0
15 кД
17 кД
41 кД
47 кД
антигены
первичный
вторичный свежий
ранний скрытый
вторичный рецидивный
57. Уровни IgМ-антител в различные периоды сифилиса
4,54
3,5
P/N
3
2,5
2
1,5
1
0,5
0
15 кД
17 кД
41 кД
47 кД
антигены
первичный
вторичный свежий
ранний скрытый
вторичный рецидивный
58. Механизм формирования ложноотрицательного результата при выявлении специфических IgM-антител
59. СТРОЕНИЕ КЛЕТОЧНОЙ СТЕНКИ T. PALLIDUM
60. Принцип РИФабс.-IgM
61. Принцип РИФабс.-IgM
62. Актуальность изучения нейросифилиса и принципов его диагностики обусловлена:
• ростом заболеваемости этой формой инфекции• смещением акцентов в сторону увеличения частоты поражения
нервной системы на ранних стадиях заболевания
• учащением скрытых форм поражения нервной системы
• неудовлетворительным состоянием исследования СМЖ у лиц с
подозрением на нейросифилис
63. Стандарты диагностики нейросифилиса в Европе (Европейские стандарты, 2003 г)
Основные тестыДополнительные тесты-индексы
Варианты РПГА в качественном
варианте:
•TPHA/MHA-TP/TP-PA
•VDRL количественная
•РИФабс (FTAabs) в качественном
варианте
•IgG-индекс (параметр внутрисиновиального синтеза
Несерологические тесты
•определение общего белка
•определение уровня альбуминов
•определение мононуклеарных
клеток
IgG, в норме <0,7)
•IgM-индекс (параметр внутрисиновиального синтеза
IgM, в норме <0,07)
•коэффициент альбумина (параметр нарушения
барьера «кровь-мозг», N <7,8)
•TPHA-индекс по Люгеру (параметр
внутрисиновиального синтеза специфических
противотрепонемных IgG.
Для их подсчета определяется соотношение
концентраций соответствующих иммуноглобулинов и
альбуминов в СМЖ)
64.
65. Стандарты диагностики нейросифилиса в США (CDC)
Основной тест• VDRL – высокоспецифичный, но не слишком
чувствительный тест
Дополнительные тесты
• РИФабс – высокочувствительная реакция
• определение лейкоцитоза
• определение белка
66. Лабораторные критерии диагноза «нейросифилис» в Европе, США и России
ЕвропаПоложительный
США
Положительный
результат TPHA/MHA- результат VDRL
TP или FTAabs
Повышение
Положительный
содержания
результат VDRL
лейкоцитов > 5/мм3
Повышение
содержания
мононуклеаров >
10/мм3
IgG-индекс ≥ 0,7
IgM-индекс ≥ 0,1
Россия
Положительные
результаты
серологических тестов
Цитоз
Белок
67. Интерпретация результатов серологического тестирования при исследовании СМЖ
Интерпретациярезультатов
серологического
тестирования при
Метод
исследовании СМЖ
результ
исследов ат
ания
РИФц.
Положит
ельный
Отрицат
ельный
Положит
ельный
Нетрепон
емные
Отрицат
тесты ельный
Интерпрет
ация
Не подтверждает
нейросифилис
Исключает
нейросифилис
В сочетании с
положительным
трепонемным
тестом с высокой
степенью
вероятности
подверждает
нейросифилис
Не исключает
нейросифилис
68.
Состояние лабораторной диагностики сифилисапутем исследования спинномозговой жидкости
(Фриго Н.В. И соавт., 2005)
33,3%
4,2%
33,3%
29,2%
Изучают состояние ликвора по всем показателям
Изучают патологию ликвора только серологическим методом
изучают патологию ликвора путем определения белка
не проводят изучение состояния ликвора
69. На основании результатов исследования ликвора выделены:
• 1 группа - резко положительныерезультаты тестирования в РСК с
двумя антигенами и РИФц. (n=15);
• 2 группа - отрицательные результаты
тестирования в РСК и РИФц. (n=51);
• 3 группа - отрицательные результаты
тестирования в РСК при резкой
позитивности РИФц. (n=12).
70.
Уровни антител подкласса IgG1 в сывороткекрови больных сифилисом
20
18
16
P/N
14
12
I
10
II
8
III
6
4
2
0
15 кД
17 кД
41 кД
трепонемные антигены
47 кД
71.
Уровни антител подкласса IgG3 в сывороткекрови больных сифилисом
9
8
7
P/N
6
I
5
II
4
III
3
2
1
0
15 кД
17 кД
41 кД
трепонемные антигены
47 кД
72.
Уровни антител подкласса IgG1 в ликворебольных сифилисом
7
6
P/N
5
I
4
II
3
III
2
1
0
15 кД
17 кД
41 кД
трепонемные антигены
47 кД
73. Уточнение варианта течения инфекции (возможно развитие нейросифилиса)
Диагностическая задачаВерификация
нейроинфекции
Используемые
серологические
показатели, ИФА
Спектр трепонемных антигенов 15, 17, 41 и
47 кД, реагирующих с СК и СМЖ
Результаты исследования
интерпретация
Примечания
Антитела в СМЖ
отсутствуют
НС исключается
корректировка
лечения не требуется
Выявлены антитела в СМЖ
(спектр антигенов
соответствует
результатам исследования СК)
НС исключается
(Позитивность
ИФА обусловлена
трансмембранным переносом
сывороточных
иммуноглобулинов)
корректировка
лечения не требуется
Выявлены антитела в СМЖ
(спектр антигенов
отличается от
результатов исследования СК)
Подтверждается
наличие НС
Требуется лечение согласно
форме нейроинфекции
74. Актуальность лабораторной диагностики раннего врожденного сифилиса обусловлена:
• Ростом числа показаний для серологическогообследования новорожденных в связи с увеличением
числа беременных с подозрением на сифилис
• Относительным увеличением скрытых форм
врожденной инфекции в структуре раннего
врожденного сифилиса
• Трудностями интерпретации результатов
серологического теститрования, обусловленными
возможностью трансплацентарного переноса плоду
материнских IgG
• Неоднозначностью так называемой «IgM-серологии»
75. Число случаев врожденного сифилиса в РФ
75
В 2008 году -249 случаев
В 2009 -190
В 2010 -175
В 2011 -128
В 2012-127 , из них умерло от данного Ds -3, мертворожденность от
данного Ds -8
В 2013-112 случаев
В 2014- 86 случаев
В 2015- 63 случая, из них 21 ранний врожденный с симптомами, 1
поздний, 41 скрытый.
Число беременных с вновь установленным диагнозом «сифилис» в
2011-4645; в 2012- 4233. (-8.9%)
Число беременных с вновь установленным диагнозом «сифилис» в
2012 г., не получивших специфического лечения до родов- 329 ( -7.6%
по сравнению с 2011)
Диагноз сифилис установлен во время родов в 2012 г. – 273 ( - 7.1% по
сравнению с 2011).
75
76. Сравнение стандартов диагностики раннего врожденного сифилиса в странах ЕС, США и России
• Для диагностики РВС в странах ЕС в настоящее времяприменяется спектр прямых и непрямых методов
исследования, включающий:
- прямые тесты (темнопольную микроскопию,
постановку ПИФ и ПЦР), материалом для которых
служат соскобы очагов поражение кожи и слизистых,
плацента, аутопсийный материал;
- серологические методы, в частности, VDRL,
количественной РПГА (TPHA/MHA-TP) и методов IgMсерологии (IgM-ИФА, IgM-иммуноблоттинг, тест 19SIgM-FTAabs).
• Для установления диагноза применяется также
исследование СМЖ ребенка путем постановки
серологических реакций (VDRL, TPHA), определение
клеток, альбумина, уровней IgM.
77. Сравнение стандартов диагностики раннего врожденного сифилиса в странах ЕС, США и России
• В СШАДостоверные критерии:
1. Клинические проявления;
2. Обнаружение T. pallidum;
3. Один из дополнительных критериев:
- Общеклинические и/или биохимические
аномалии ЦСЖ (при отсутствии других
причин);
- Положительные нетрепонемные тесты с ЦСЖ;
- Обнаружение IgM-антител
78. Сравнение стандартов диагностики раннего врожденного сифилиса в странах ЕС, США и России
В России
1. Клинические проявления
2. Исследование плаценты:
- макроскопическое
- микроскопическое
3. Анамнез (отсутствие лечения, неполноценное,
запоздалое лечение матери во время
беременности)
4. Рентгенография длинных трубчатых костей
5. Общеклинические, биохимические и серологические
исследования
79. Сравнение стандартов диагностики РВС, принятых в странах Европы, США и России
Общим для всех стратегийтестирования является:
• Приоритет прямых методов
исследования, признаваемых главными
в подтверждении диагноза
• Использование количественных
вариантов ТТ и НТТ
• Сопоставление результатов
обследования матери и ребенка.
80. Интерпретация результатов серологического тестирования матери и новорожденного ребенка (диагностика врожденного сифилиса) (Sung
L., MacDonald N.E., 1998)Результаты исследований
№ п.п.
1.
2.
3.
4.
5.
Нетрепонемные тесты
Трепонемные тесты
Интерпретация
мать
ребенок
мать
ребенок
–
–
–
–
- сифилиса нет ни у матери, ни
у ребенка
–
- сифилиса нет.
- ложноположительная реакция в нетрепонемном тесте у
матери и ребенка (связана с
пассивной передачей антител
через плаценту)
+
- сифилис у матери, ребенок
возможно инфицирован
- мать получала противосифилитическое лечение в
период беременности
+
- ранний сифилис у матери,
возможно
инфицирование
ребенка
+
- мать полностью излечена до
или на ранних периодах
беременности
у
матери
ложноположительная
реакция
в
трепонемных тестах (например
при болезни Лайма)
+
+
+
–
+
+ или –
+
–
–
+
+
+
81. АЛГОРИТМ ОЦЕНКИ ГЕНЕТИЧЕСКОГО ПОЛИМОРФИЗМА В ПРОФИЛАКТИКЕ И ДИАГНОСТИКЕ ИНФЕКЦИОННЫХ ЗАБОЛЕВАНИЙ
Генетическиефакторы
Фенотипические
факторы
Предрасположенность
к инфекции
Геномный анализопределение SNP
Риск развития
заболевания
Течение
заболевания
Исход
заболевания
82.
83. Специфичность распознавания ПАМП различными TLR
ПАМПТриацетилированные липопептиды (липогликаны
липоманнан и липоарабиноманнан),
фосфатидилинозитолдиманнозид и липопротеин
19 кД)
Диацетилированные липопептиды
Патоген
Mycobacterium tuberculosis
Mycobacterium leprae
Leptospira interrogans, Porphyromonas gingivalis, Helicobacter
pylori
Белки вирусной оболочки
цитомегаловирус, вирус кори, вирус герпеса HSV-1
Гликозилфосфатидилинозитол
простейшие (Trypanosoma cruzi, Trypanosoma brucei,
Toxoplasma gondii, Leishmania major, Plasmodium falciparum)
Грам-позитивные бактерии (Staphylococcus aureus,
Streptococcus pneumoniae)
грибы (дрожжи)
Treponema pallidum
вирусы и бактерии
TLR3
RSV
Бактериальный флагеллин
Legionella pneumophila, Salmonella typhimurium
REP-последовательности ДНК
TLR1/TLR2,
TLR2/TLR6
Грам-негативные бактерии
Гликозилфосфатидилинозитол
CpG ДНК
TLR2
Staphylococcus epidermis
простейшие (Trypanosoma cruzi, Trypanosoma brucei,
Toxoplasma gondii, Leishmania major и Plasmodium falciparum)
Одноцепочечная РНК
TLR1/TLR2
TLR2/TLR6
Липополисахарид
Липопротеины, пептидогликаны, липотейхоевые
кислоты
Зимозан
Гликолипиды
Модулин
Двуцепочечная РНК
Липополисахарид
F(fusion)-протеин вирусной оболочки
Рецептор
вирус HCV
Mycobacterium tuberculosis, вирусы HCV, HIV-1, RSV
вирусы герпеса HSV-1 и HSV-2, HIV, простейшие (Trypanosoma
cruzi, Trypanosoma brucei, Toxoplasma gondii, Leishmania major
и Plasmodium falciparum)
Salmonella typhimurium, Escherichia coli, Salmonella enterica,
Pseudomonas aeruginosa, Neisseria meningitidis
TLR4
TLR5
TLR7
TLR8
TLR9
84. Генетический полиморфизм рецепторов TLR-семейства
ГенTLR1
TLR2
TLR6
TLR4
TLR5
TLR7
Полиморфизм
гена
1805G/T
944C/Т
743A/G
914A/Т
Полиморфизм белка
Фенотипическая ассоциация
серин-602/изолейцин
пролин-315/лейцин
аспарагин-248/серин
гистидин-305/лейцин
Туберкулез, лепра
2408G/A
аргинин-753/глутамин
2180C/T
аргинин-677/триптофан
2021C/A
пролин-631/гистидин
597T/C
аспарагин-199/аспарагин
745Т/С
752Т/А
2069А/С
460/461Del AATAA
896A/G
пролин-680/гистидин
серин-249/пролин
лейцин-251/стоп-кодон
аспарагин-690/треонин
?
аспарагин-299/глицин
1196C/T
треонин-399/изолейцин
1174С/Т
32A/T
2403G/A
аргинин-392/стоп-кодон
?
?
септический шок, туберкулез,
менингит,
лепра, остеомиелит
туберкулез, менингит, лепра
(особенно
лепроматозная)
системная менингококкемия
туберкулез (особенно
милиарный)
Туберкулез
Грам-негативные инфекции, в
том числе сепсис и
септический шок, вирус RSV
пневмония
хроническая HCV-инфекция
85. Полиморфизм TLR2 2408G/A (замена аргинина-753 на глутамин в TIR-домене)
- встречается у представителей белой расы счастотой 9–10%;
- нарушает
функцию
рецептора
и
ассоциирован с гипореактивностью на
белковые антигены Borrelia burgdorferi и
Treponema pallidum.
86.
87.
88.
89.
90.
6.15. Водители ипешеходы должны
выполнять требования
сигналов и
распоряжения
регулировщика, даже
если они противоречат
сигналам светофора,
требованиям дорожных
знаков или разметки.
91.
92.
БЛАГОДАРЮ ЗАВНИМАНИЕ!

![Заболеваемость сифилисом в Российской Федерации (на 100 тыс. нас.) [1975-2015 гг.] Заболеваемость сифилисом в Российской Федерации (на 100 тыс. нас.) [1975-2015 гг.]](https://cf5.ppt-online.org/files5/slide/2/20qtfDIGelAiRHdU8pvucQWb4JrXzoxLyMYVjB/slide-1.jpg)

Медицина
Медицина








